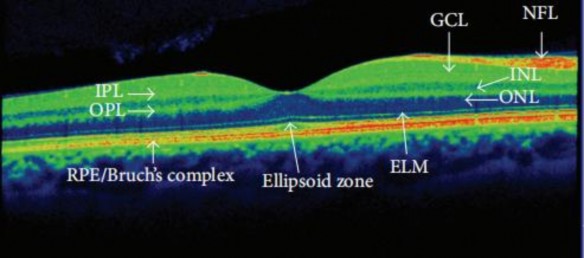
Hình 1 11 Các lớp võng mạc vùng hoàng điểm bình thường trên OCT 30 RPE Bruch’s 5

- Vi phình mạch: vi phình mạch là dấu hiệu lâm sàng đầu tiên có thể phát hiện khi soi đáy mắt, xuất hiện những chấm tròn nhỏ thường nằm ở phía thái dương của hoàng điểm và đôi khi khó phân biệt với chấm xuất huyết. Các vi phình mạch có thể tồn tại trong suốt các giai đoạn của bệnh võng mạc ĐTĐ, đây là triệu chứng đặc trưng của bệnh võng mạc ĐTĐ.

Hình 1. 7: Vi phình mạch trên ảnh màu đáy mắt (Nguồn ảnh: Jack Kanski, Bowling B - 2015)[32]
- Xuất tiết
+. Xuất tiết cứng: nằm ở giữa lớp rối trong và lớp nhân trong của võng mạc, với những hình dạng khác nhau, màu sáp vàng, ranh giới với các vùng xung quanh rõ. Bản chất của xuất tiết cứng là chất lắng đọng lipoprotein, có nguồn gốc từ huyết tương do quá trình phù võng mạc và phù hoàng điểm lâu dài.

Hình 1. 8: C: xuất tiết cứng kèm theo vi phình mạch; D: xuất tiết cứng (Nguồn ảnh: Jack Kanski, Bowling B - 2015)[32]
+. Xuất tiết mềm: nguyên nhân do tắc mao mạch trong lớp sợi thần kinh võng mạc gây tổn thương sợi trục thần kinh, tạo nên xuất tiết mềm (hay xuất tiết bông). Trên lâm sàng khi soi đáy mắt thấy những đám mờ ranh giới không rõ, thường nằm ở chỗ phân nhánh của mạch máu võng mạc.
- Xuất huyết: xuất huyết trong võng mạc, thường xuất hiện từ tận cùng của mao tĩnh mạch, có hình dạng chấm hay dạng nốt màu đỏ tươi.

Có thể bạn quan tâm!
-
Đặc điểm lâm sàng và phim OCT của bệnh nhân phù hoàng điểm do đái tháo đường tại Bệnh viện Mắt trung ương - 1 -
Đặc điểm lâm sàng và phim OCT của bệnh nhân phù hoàng điểm do đái tháo đường tại Bệnh viện Mắt trung ương - 2 -
Phân Loại Bệnh Nhân Theo Đặc Điểm Sử Dụng Insulin -
Mô Tả Đặc Điểm Lâm Sàng Bệnh Nhân Phù Hoàng Điểm Do Đái Tháo Đường -
Độ Dày Vmtt Trung Bình Của Nhóm Huyết Áp Cao Và Huyết Áp Bình Thường
Xem toàn bộ 66 trang tài liệu này.
Hình 1. 9:C: chấm, nốt xuất huyết võng mạc; D: đám nhồi máu võng mạc (Nguồn ảnh: Jack Kanski, Bowling B - 2015)[32]
- Tân mạch võng mạc: tân mạch võng mạc được coi là tiêu chuẩn của bệnh võng mạc ĐTĐ tăng sinh. Bệnh võng mạc ĐTĐ gây thiếu hụt tế bào nội mô của mạch máu võng mạc, đặc biệt ở các mao tĩnh mạch và các tĩnh mạch nhỏ võng mạc. Tân mạch bắt đầu phát triển từ màng ngăn trong của tế bào nội mô võng mạc, đi qua chỗ thiếu hụt tế bào nội mô của mạch máu võng mạc để tiến vào buồng dịch kính.

Hình 1. 10: Tân mạch võng mạc
(Nguồn ảnh: Jack Kanski, Bowling B - 2015)[32]
1.2.4.2. Chụp cắt lớp võng mạc (OCT):
- Các lớp võng mạc vùng hoàng điểm bình thường trên OCT:
Hình 1. 11: Các lớp võng mạc vùng hoàng điểm bình thường trên OCT [30]
(RPE/Bruch’s complex: Lớp biểu mô sắc tố/màng Bruch, Ellipsoid zone: lớp tế bào quang thụ, ELM: lớp giới hạn ngoài, ONL: lớp hạt ngoài, OPL: lớp rối ngoài,
INL: lớp hạt trong, IPL: lớp rối trong, GCL: lớp tế bào hạch, NFL: lớp sợi thần kinh.)
- Đánh giá phù hoàng điểm trên OCT theo bề dày võng mạc:
+. Không phù hoàng điểm: hình ảnh hoàng điểm bình thường và bề dày không đạt mức phù hoàng điểm tiền lâm sàng.
+. Phù hoàng điểm: võng mạc dày và có các đặc trưng hình thái điển hình của phù hoàng điểm.
- Đánh giá phù hoàng điểm trên OCT theo hình thái võng mạc:
+. Phù hoàng điểm không dạng nang: tăng độ dày võng mạc, giảm phản xạ trong võng mạc, mất tính đều đặn của các lớp võng mạc, hố trung tâm phẳng, không có các khoang dạng nang.
+. Phù hoàng điểm dạng nang: ngoài các tiêu chuẩn trên, kèm theo sự hiện diện của các khoang dạng nang trong võng mạc.

Hình 1. 12: Phù hoàng điểm dạng nang (Nguồn ảnh: www.researchgate.net )
1.3. Một số yếu tố liên quan đến phù hoàng điểm do đái tháo đường
Nhiều nghiên cứu đã chỉ ra những yếu tố nguy cơ cho sự gia tăng các biến chứng trên bệnh ĐTĐ như thời gian mắc bệnh, mức độ tăng đường huyết, mức độ kiểm soát đường huyết, huyết áp, trình độ văn hóa, hoàn cảnh kinh tế, giới tính, chủng tộc, mức độ tăng lipid máu, người nghiện thuốc lá, nghiện rượu. Trong đó, một số yếu tố chính liên quan đến phù hoàng điểm do ĐTĐ là thời gian mắc ĐTĐ, kiểm soát đường huyết, tình trạng huyết áp và hoàn cảnh kinh tế - xã hội, trình độ văn hóa của bệnh nhân.
1.3.1. Thời gian mắc đái tháo đường
Thời gian mắc ĐTĐ là yếu tố nguy cơ hàng đầu và là yếu tố tiên đoán sự phát triển của bệnh võng mạc ĐTĐ. Nghiên cứu dịch tễ học về bệnh võng mạc ĐTĐ ở Wiscosin[18] đã chỉ ra: 8% số bệnh nhân mắc đái tháo đường trong 3 năm đầu mắc bệnh võng mạc đái tháo đường, 25% xảy ra trong 5 năm tiếp theo, 60% ở 10 năm và 80% ở bệnh nhân 15 năm mắc bệnh ĐTĐ. Do đó có thể nói tỷ lệ mắc bệnh võng mạc ĐTĐ cao lên cùng sự tăng lên của thời gian mắc ĐTĐ.
1.3.2. Kiểm soát đường huyết
Yếu tố nguy cơ được biết đến nhiều nhất của phù hoàng điểm ĐTĐ là tăng đường máu mạn tính, thường lớn hơn 120 mg/dl và đôi khi vượt quá 200 mg/dl trong ĐTĐ. Tăng đường huyết kéo dài trực tiếp làm tổn thương tế bào nội mô mạch máu và làm tổn thương hàng rào máu-võng mạc, do đó dẫn đến thoát mạch và phù hoàng điểm do dịch chảy vào vượt quá dịch thoát ra.
Nghiên cứu dịch tễ học cho thấy thời gian bị ĐTĐ làm tăng tỷ lệ phù hoàng điểm. Nhóm nghiên cứu dịch tễ học bệnh võng mạc đái tháo đường Winconsin (WESDR)[18] đã báo cáo sự gia tăng tỷ lệ của phù hoàng điểm ĐTĐ với thời gian mắc ĐTĐ lâu hơn. Ví dụ, giữa 4 và 14 năm mắc ĐTĐ thì WESDR[18] thấy rằng phù hoàng điểm tăng từ 8,2% đến 26,1% những người bị ĐTĐ týp I.
Insulin có vai trò quan trọng trong kiểm soát đường máu ở cả bệnh nhân ĐTĐ týp I và II. Tuy nhiên, một vài nghiên cứu đã chỉ ra rằng sử dụng insulin có thể làm tăng nguy cơ bệnh VMĐTĐ và phù hoàng điểm ĐTĐ. Henricsson[19] và cộng sự đã thấy rằng 100% bệnh nhân ĐTĐ tăng nguy cơ phù hoàng điểm khi điều trị với insulin so với dùng thuốc trong số 333 bệnh nhân được điều trị insulin. Tương tự thì Zapata và cộng sự[21] thấy rằng người bệnh ĐTĐ týp II được điều trị insulin đã tăng độ dày hoàng điểm. Cơ chế bệnh học có thể do tăng sự biểu hiện của VEGF hoặc hiệu quả hoạt hóa mạch của insulin và sự cải thiện đột ngột trong kiểm soát đường máu làm tổn thương thêm hàng rào máu-võng mạc vốn đã tổn thương từ trước. Bởi vậy, sử dụng insulin là quan trọng để điều trị
ĐTĐ tuy nhiên cần cân nhắc tác dụng phụ lên mắt và vai trò tiềm ẩn trong phù hoàng điểm ĐTĐ.
1.3.3. Tăng huyết áp
Một yếu tố nguy cơ khác liên quan đến phù hoàng điểm ĐTĐ là tăng huyết áp mạn tính, gây tổn hại đến lớp tế bào nội mô, dẫn đến những thay đổi về cấu trúc của mạch máu và những rối loạn chức năng mạch máu khác. Nhiều nghiên cứu đã cho thấy mối liên quan giữa tăng áp lực dòng máu với tăng nguy cơ của phù hoàng điểm ĐTĐ, mặc dù khó thiết lập mối quan hệ nhân quả vì ĐTĐ và tăng huyết áp thường tiến triển song hành.
Các nghiên cứu dịch tễ học cho thấy có mối liên quan chặt chẽ giữa tăng huyết áp và phù hoàng điểm ĐTĐ. Nghiên cứu WESDR[18] đã trình bày mối liên quan giữa tăng huyết áp tâm trương và tăng nguy cơ phù hoàng điểm. Tương tự, trong nghiên cứu gồm 112 bệnh nhân mắc phù hoàng điểm ĐTĐ, Lopes de Faria và cộng sự[15] đã tìm thấy tỷ lệ phù hoàng điểm ĐTĐ cao hơn ở bệnh nhân tăng huyết áp. Đặc biệt, cứ tăng 10mmHg huyết áp tâm thu trên 160mmHg làm tăng nguy cơ phù hoàng điểm lên 23%. Như vậy, cùng việc kiểm soát đường huyết, điều quan trọng là phải theo dõi và quản lý huyết áp ở bệnh nhân ĐTĐ để ngăn chặn sự gia tăng tổn thương của võng mạc và hoàng điểm.
1.3.4. Hoàn cảnh kinh tế, trình độ văn hóa
Đối với bệnh nhân đái tháo đường, các yếu tố hoàn cảnh kinh tế - xã hội, địa bàn dân cư, trình độ văn hóa có tác động rất lớn và liên quan mật thiết đến chất lượng dịch vụ y tế, khả năng điều chỉnh đường huyết, khả năng ngăn chặn các biến chứng. Những bệnh nhân đái tháo đường có hoàn cảnh kinh tế kém, sống xa trung tâm, trình độ hiểu biết thấp dễ mắc các biến chứng của bệnh đái tháo đường hơn do mức độ tuân thủ điều trị thấp, kém tiếp cận với các dịch vụ y tế. Trong một nghiên cứu gồm 22345 bệnh nhân ĐTĐ tại Malaysia, Naserrudin [22] đã chỉ ra trình độ dân trí thấp, mức độ nghèo đói của địa phương gây hạn chế kiến thức trong kiểm soát ĐTĐ là yếu tố nguy cơ của bệnh võng mạc ĐTĐ.
1.4. Tình hình nghiên cứu phù hoàng điểm trên Thế giới và tại Việt Nam
1.4.1. Tình hình nghiên cứu phù hoàng điểm trên Thế giới
Nghiên cứu trên quy mô toàn cầu của Yau và cộng sự (2012)[16] ước tính có tới 21 triệu người trên toàn Thế giới có tổn thương hoàng điểm ĐTĐ trong tổng số 93 triệu người mắc ĐTĐ, và chiếm tới 12% các trường hợp mù mới mắc hàng năm. Nghiên cứu của Wong và cộng sự (2006)[34] tại Mỹ trên 778 bệnh nhân mắc ĐTĐ độ tuổi từ 45 đến 85 cũng cho thấy có 9% bệnh nhân có phù hoàng điểm ĐTĐ, đe dọa thị lực của bệnh nhân. Báo cáo tại một số quốc gia khác cũng cho thấy tỷ lệ tương đồng về tỷ lệ tổn thương hoàng điểm trên bệnh nhân ĐTĐ. Hầu hết các nghiên cứu trên đều là các nghiên cứu dịch tễ học trên số lượng bệnh nhân rất lớn.
Tỷ lệ phù hoàng điểm do đái tháo đường liên quan chủ yếu tới thời gian mắc bệnh. Ở những bệnh nhân mắc đái tháo đường sớm, trong 5 năm đầu tỷ lệ phù hoàng điểm là 0%, tăng lên 3% sau 10 năm và lên tới 29% sau 20 năm. Với những bệnh nhân mắc đái tháo đường muộn, tỷ lệ phù hoàng điểm là 3% sau 5 năm và 28% sau 20 năm.[17]
Ngoài ra, các yếu tố như tăng huyết áp, chỉ số HbA1c, sử dụng insulin trong điều trị, rối loạn mỡ máu được coi là các yếu tố nguy cơ của tổn thương hoàng điểm ĐTĐ.
1.4.2. Tình hình nghiên cứu phù hoàng điểm tại Việt Nam
Bùi Tiến Hùng (2002)[27] nghiên cứu các hình thái tổn thương võng mạc trong bệnh đái tháo đường trên 194 mắt ở bệnh nhân ĐTĐ thấy có 106 mắt phát hiện có phù hoàng điểm.
Nguyễn Phước Hải (2020)[26] nghiên cứu đặc điểm lâm sàng và cận lâm sàng của bệnh nhân phù hoàng điểm do đái tháo đường trên 98 mắt ở 61 bệnh nhân ĐTĐ thấy triệu chứng nhìn mờ và ám điểm là những triệu chứng thường gặp nhất. Ngoài ra, nghiên cứu này còn chỉ ra mối liên quan giữa phù hoàng điểm ĐTĐ với giới tính, giai đoạn tiến triển của bệnh võng mạc đái tháo đường và những tổn thương võng mạc phối hợp.
Nghiên cứu của Nguyễn Trọng Khải (2018)[28] trên 784 đối tượng chỉ ra các yếu tố liên quan đến bệnh võng mạc đái tháo đường bao gồm
sinh sống ở nông thôn, có trình độ học vấn thấp, thời gian mắc bệnh ĐTĐ dài, hiệu quả điều trị ĐTĐ kém, người thừa cân, người gầy, THA và người có kiến thức, thực hành kém về bệnh ĐTĐ hoặc bệnh võng mạc ĐTĐ.
Nghiên cứu của Hoàng Thị Phúc, Vũ Tuấn Anh (2012)[1] về điều trị laser trên bệnh nhân phù hoàng điểm ĐTĐ bằng laser 532nm tại Bệnh viện Mắt Trung ương, chủ yếu đánh giá về hiệu quả điều trị laser trên bệnh nhân phù hoàng điểm.





